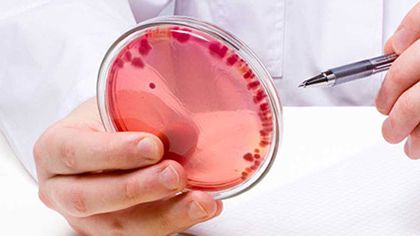
Ad:  hematoloji-3.jpg
Gsterim: 698
Boyut:  14.6 KB

Hematoloji

Hematoloji, kanın yapısı, işlevi ve hastalıklarını konu alan tıp dalı. 17. yüzyılda ilkel, tek mercekli bir mikroskop kullanarak kandaki alyuvarlan inceleyen ve büyüklüklerini bir kum taneciğiyle karşılaştıran Felemenkli Antonie van Leeuwenhoek, kanın bileşimine bilimsel bir açıklama getiren ilk bilim adamı oldu. 18. yüzyılda İngiliz fizyolog William Hewson alyuvarları ayrıntılı olarak tanımladı, lenf sistemini inceledi ve fibrinin pıhtılaşmadaki rolünü gösterdi. 19. yüzyılda, kan hücrelerinin kemik iliğinde oluştuğu anlaşıldı; öldürücü kansızlık, lösemi ve bir dizi kan hastalığı tanımlandı. Kandaki hücrelerin boyanması için çeşitli tekniklerin geliştirilmesiyle birlikte hematolojide morfoloji dönemi başladı.
Sponsorlu Bağlantılar
20. yüzyılın ilk yıllarında pek çok tıp öğrencisi kan hastalıklarında kanın yapısında oluşan değişikliklerle ilgilendi. O, A, B ve AB kan gruplarının bulunması, kan naklinde uygun olmayan kan verilmesi durumunda ortaya çıkan komplikasyonların önüne geçilmesini sağladı. Hematokrit işleminin kullanılmaya başlaması, 1932’de alyuvarlardaki hemoglobin düzeyinin ve alyuvar hacminin ölçülmesi kansızlık konusundaki incelemeleri hızlandırdı.
Hematolojide fizyoloji dönemi, 1920’lerde çeşitli besinlerin alyuvar yapımındaki rolünün sistemli olarak araştırılmasıyla başladı. Bu araştırmalar, karaciğer özütünün öldürücü kansızlığın tedavisinde yararlı olduğunu, karaciğerde bulunan B12 vitamininin kansızlığa karşı etkin bir madde olduğunu kanıtladı. Beslenme ve biyokimya alanlarında buna koşut giden buluşlar ile ağır ve radyoaktif izotopların kullanılması, hemoglobin yapımının ve hastalıklarda hemoglobin yapısında ortaya çıkan değişikliklerin anlaşılmasına yardımcı oldu.
II. Dünya Savaşı’ndan sonra hematolojinin ilgi alanı genişledi. Orak hücreli kansızlığın incelenmesi, normal bir proteinde molekül düzeyinde oluşan değişikliğin hastalığa özgü tüm belirtilerin temel nedeni olabileceğini ortaya koydu. Aynı dönemde protein ve enzim kimyası tekniklerindeki gelişmeler, hemoglobinin bireşimlenmesinde daha önce hiç fark edilmeyen birçok bozukluğun tanınmasını sağladı; bu bozuklukların genlerle denetlendiği gösterildi. Özellikle kalıtımla geçen kansızlıklar üzerinde yapılan çalışmalar antropologlara önemli genetik bulgular sağladı.
II. Dünya Savaşı’ndan bu yana elektron mikroskopu kullanılarak ve biyokimya alanındaki ilerlemelerden yararlanılarak yapılan araştırmalar, lösemi ve lenfomalarda ışınımın, çeşitli kimyasal maddelerin ve virüslerin rolünün ortaya çıkarılmasına, kan hücrelerinin bireşimlenmesinde ortaya çıkan yapısal değişikliklerin daha ayrıntılı olarak araştırılmasına ve trombositlerin ve pıhtılaşma sürecinin incelenmesine olanak sağladı.
MsXLabs.org & Ana Britannica
Son düzenleyen _Yağmur_; 2 Aralık 2016 12:55
"İnşallah"derse Yakaran..."İnşa" eder YARADAN.

 Hematoloji (Kan Bilimi)
Hematoloji (Kan Bilimi)